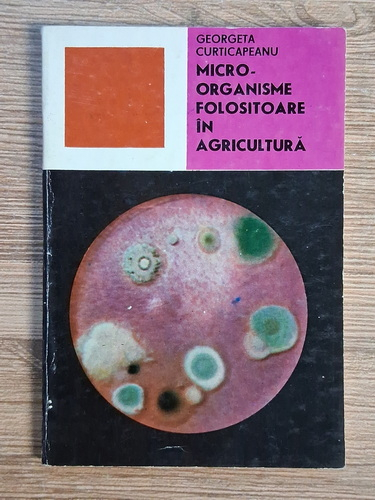

Georgeta Curticapeanu - Microorganisme folositoare in agricultura

Autor: Georgeta Curticapeanu
Titlu: Microorganisme folositoare in agricultura
Editura: Stiintifica
An de aparitie: 1973
Nr. pagini: 110
Format: 11 x 16 cm
Coperti: brosate
Carte in limba: romana
Stare: buna
Titlu: Microorganisme folositoare in agricultura
Editura: Stiintifica
An de aparitie: 1973
Nr. pagini: 110
Format: 11 x 16 cm
Coperti: brosate
Carte in limba: romana
Stare: buna
FIECARE CARTE este atent verificată înainte de punerea în vânzare
+70.000 CĂRŢI sunt acum în stocul nostru
>10.000 CĂRŢI se găsesc doar la noi în magazin
TRANSPORT GRATUIT la comenzile de minimum 199 lei
DREPT DE RETUR în 14 zile
Produse din aceeasi categorie

sus